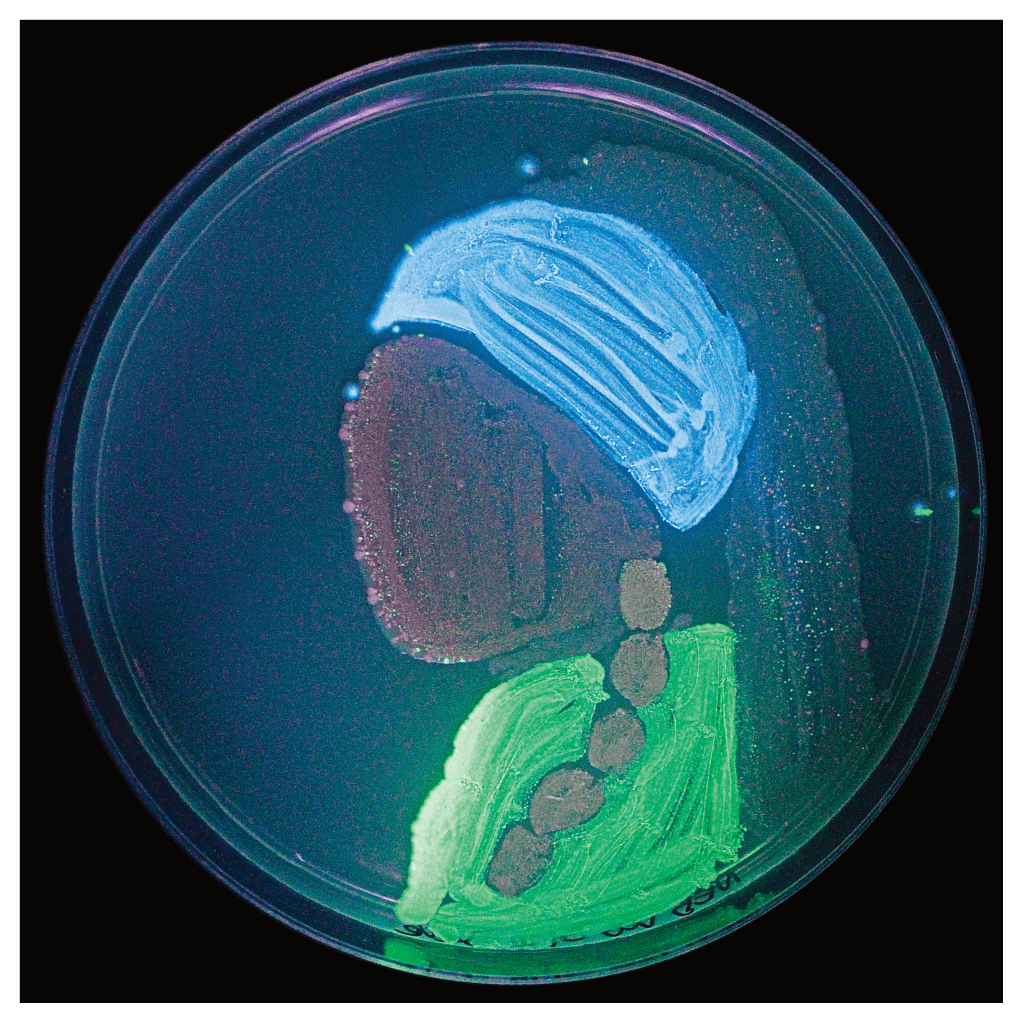

G A L E R I E
Ein Überblick.
Kunst und Kultur
Die Produkte aus Jahrhunderten des künstlerischen Schaffens und Kulturen von mikroskopischer Größe, die nicht einmal zwei Tage alt sind.
Kleine Geschichten.
Radiergummis, die Geschichten erschaffen, statt Spuren zu verwischen. Und das alles auf kleinstem Raum.


Ideale
Man kann nach Idealen streben. Muss man aber nicht. Um diesen tiefgründigen Entscheidungen einen Rahmen zu geben, wurden sie auf Leinwände gemalt.
Art Distribution System
Ein neuer Ansatz um Kunst an die Menschen zu bringen, unter den Massen zu verteilen und unter deren Haut zu gelangen.

kontakt@konstantinsauer.com
© 2025 Konstantin Sauer. Alle Rechte vorbehalten.
